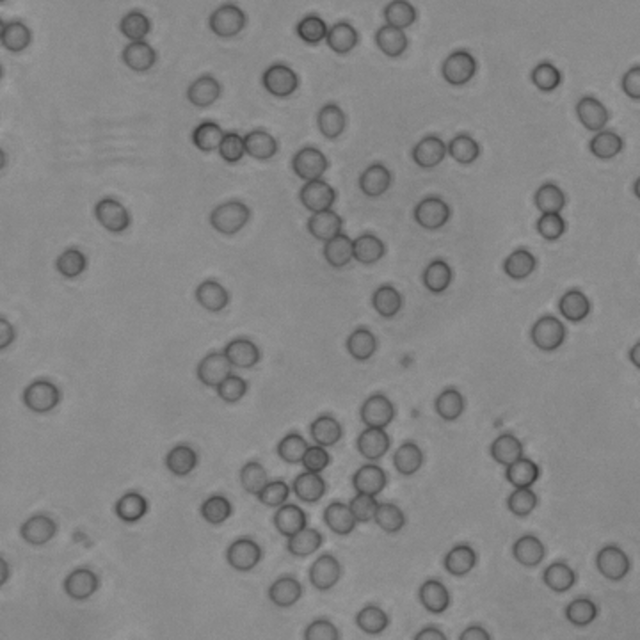
dlabflow-yolo-onnx-react-rbc

브라우저에서 동작하는 실시간 적혈구 탐지 데모
· 약 3분
본 포스트에서는 D-Lab Flow에서 학습한 YOLO 기반 적혈구 탐지 모델을 ONNX 형식으로 변환하고,
이를 브라우저에서 실시간 객체 탐지로 구현하는 방법을 소개합니다.
결과물 소개
이 글을 통해 아래 내용을 학습할 수 있습니다
- D-Lab Flow를 활용한 객체 탐지 모델 생성
- YOLO 모델을 ONNX로 변환하여 웹에서 활용하기
- React 기반 실시간 적혈구 탐지 웹 애플리케이션 구현

스마트폰으로 접속 후 아래 이미지를 카메라로 비추면 적혈구 탐지가 실시간으로 실행됩니다.
촬영 거리를 조절하며 탐지 변화를 확인해보세요.
D-Lab Flow에서 모델 생성 하기
1. 저장소 생성
이미지 형식으로 저상소를 생성합니다.

2. 이미지 파일 업로드
아래 데이터셋을 다운로드하여 RBC_images 폴더를 업로드합니다.

3. 데이터셋 생성
이미지 유형으로 데이터셋을 생성합니다.

4. 라벨링 파일 업로드 및 라벨링 작업
첨부된 RBC_annotations 폴더를 업로드합니다.

라벨링 상태를 확인합니다.

5. 프로젝트 생성
객체탐지 타입의 프로젝트를 생성합니다.

6. 인공지능 학습
학습할 버전을 생성하고 모델을 지정하여 학습을 진행합니다.

하이퍼파라미터 설정 값 및 다양한 모델을 사용하여 학습을 해보고 성능지표를 비교합니다.

적혈구 객체탐지 데모 만들기
1. 모델 가중치를 onnx 파일로 변환
D-Lab Flow에서 학습 완료된 best.pt 모델을 다운로드합니다. Ultralytics 저장소를 클론하여 ONNX 변환을 수행합니다.

아래 절차는 YOLOv8 이후 모델(YOLOv8, v9, v11) 모두 지원합니다.
git clone https://github.com/ultralytics/ultralytics.git
cd ultralytics
pip install ultralytics onnx onnxruntime
CLI 방식으로 변환
yolo export model=best.pt format=onnx
2. 데모 프로젝트 다운로드
실시간 객체 탐지 데모 프로젝트를 클론하고 필요한 의존성을 설치합니다
git clone https://github.com/grit-docs/dlabflow-yolo-onnx-react.git
cd dlabflow-yolo-onnx-react
npm install
변환된 onnx 모델 파일을 복사 후 이름을 model.onnx 로 변경하여 아래 경로에 저장합니다
public/models/model.onnx
웹앱을 실행합니다.
npm run dev
완성된 적혈구 객체 탐지 데모 GitHub 저장소
https://github.com/grit-docs/dlabflow-yolo-onnx-react-rbc.git
